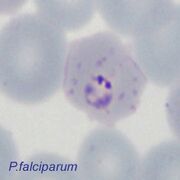

File list
This special page shows all uploaded files.
| Date | Name | Thumbnail | Size | User | Description | Versions |
|---|---|---|---|---|---|---|
| 15:52, 14 November 2024 | ET stage 2.jpg (file) |  |
48 KB | Admin | 1 | |
| 15:51, 14 November 2024 | LT size 2.jpg (file) |  |
146 KB | Admin | 1 | |
| 15:51, 14 November 2024 | LT size 1.jpg (file) |  |
32 KB | Admin | 1 | |
| 15:50, 14 November 2024 | LT dots 2.jpg (file) | |
52 KB | Admin | 1 | |
| 15:50, 14 November 2024 | LT dots 1.jpg (file) |  |
46 KB | Admin | 1 | |
| 15:49, 14 November 2024 | ET stage 1c.jpg (file) |  |
173 KB | Admin | 1 | |
| 15:49, 14 November 2024 | ET Hb metabolism-label.jpg (file) |  |
153 KB | Admin | 1 | |
| 15:49, 14 November 2024 | ET Hb metabolism.jpg (file) |  |
146 KB | Admin | 1 | |
| 15:42, 14 November 2024 | New Malaria Lifecycle.jpg (file) |  |
211 KB | Admin | 1 | |
| 19:54, 28 October 2024 | RDT multi posPF2.jpg (file) |  |
38 KB | Admin | 1 | |
| 19:54, 28 October 2024 | RDT multi posPF1.jpg (file) |  |
40 KB | Admin | 1 | |
| 19:54, 28 October 2024 | RDT multi pan1.jpg (file) |  |
38 KB | Admin | 1 | |
| 19:53, 28 October 2024 | RDT multi neg.jpg (file) |  |
36 KB | Admin | 1 | |
| 19:53, 28 October 2024 | RDT multi fail4.jpg (file) |  |
39 KB | Admin | 1 | |
| 19:53, 28 October 2024 | RDT multi fail3.jpg (file) |  |
38 KB | Admin | 1 | |
| 19:53, 28 October 2024 | RDT multi fail2.jpg (file) |  |
39 KB | Admin | 1 | |
| 19:52, 28 October 2024 | RDT multi fail1.jpg (file) |  |
38 KB | Admin | 1 | |
| 17:15, 9 October 2024 | RDT multi pos2.jpg (file) |  |
39 KB | Admin | 1 | |
| 10:54, 9 October 2024 | RDT multi pos1.jpg (file) |  |
39 KB | Admin | 1 | |
| 17:16, 7 October 2024 | RDT multi no band4.jpg (file) |  |
39 KB | Admin | 1 | |
| 17:16, 7 October 2024 | RDT multi no band3.jpg (file) |  |
39 KB | Admin | 1 | |
| 17:15, 7 October 2024 | RDT multi no band2.jpg (file) |  |
39 KB | Admin | 1 | |
| 17:14, 7 October 2024 | RDT multi no band1.jpg (file) |  |
38 KB | Admin | 1 | |
| 10:06, 24 September 2024 | RDT single two band+.jpg (file) |  |
36 KB | Admin | 1 | |
| 10:03, 24 September 2024 | Contol RDT neg.jpg (file) |  |
36 KB | Admin | 1 | |
| 15:34, 15 September 2024 | RDT single no band+.jpg (file) |  |
35 KB | Admin | 1 | |
| 15:26, 15 September 2024 | RDT single no band.jpg (file) |  |
35 KB | Admin | 1 | |
| 11:00, 23 August 2024 | RDT multi.jpg (file) |  |
37 KB | Admin | 2 | |
| 11:00, 23 August 2024 | RDT single.jpg (file) |  |
35 KB | Admin | 2 | |
| 10:16, 9 July 2024 | 4 PF RDT neg.jpg (file) |  |
42 KB | Admin | 1 | |
| 10:15, 9 July 2024 | 4 RDT work.jpg (file) |  |
45 KB | Admin | 1 | |
| 09:40, 9 July 2024 | 0 PF RDT.jpg (file) |  |
54 KB | Admin | 1 | |
| 22:50, 27 June 2024 | 1 PF RDT pre.jpg (file) |  |
51 KB | Admin | 1 | |
| 08:25, 27 June 2024 | 2 RDT work b.jpg (file) |  |
30 KB | Admin | 1 | |
| 22:18, 26 June 2024 | 2 RDT work.jpg (file) |  |
44 KB | Admin | 1 | |
| 09:15, 26 June 2024 | 3 RDT work.jpg (file) |  |
48 KB | Admin | 1 | |
| 17:52, 25 June 2024 | 3 PF RDT pos.jpg (file) |  |
42 KB | Admin | 1 | |
| 09:15, 19 June 2024 | Liver 3.jpg (file) |  |
127 KB | Admin | 1 | |
| 09:14, 19 June 2024 | Liver 2.jpg (file) |  |
99 KB | Admin | 1 | |
| 09:14, 19 June 2024 | Liver 1.jpg (file) |  |
79 KB | Admin | 1 | |
| 09:14, 19 June 2024 | Liver 0.jpg (file) |  |
82 KB | Admin | 1 | |
| 10:18, 18 June 2024 | UK.jpg (file) |  |
25 KB | Admin | 2 | |
| 09:49, 18 June 2024 | Lifecycle.jpg (file) |  |
211 KB | Admin | 1 | |
| 09:38, 18 June 2024 | Esp.jpg (file) |  |
17 KB | Admin | 1 | |
| 11:32, 17 June 2024 | List.jpg (file) |  |
67 KB | Admin | 1 | |
| 11:32, 17 June 2024 | Gallery.jpg (file) |  |
48 KB | Admin | 1 | |
| 11:26, 17 June 2024 | Species.jpg (file) |  |
63 KB | Admin | 1 | |
| 11:22, 17 June 2024 | RDT.jpg (file) |  |
81 KB | Admin | 1 | |
| 11:04, 17 June 2024 | Thick.jpg (file) |  |
38 KB | Admin | 1 | |
| 10:53, 17 June 2024 | Biology.jpg (file) |  |
40 KB | Admin | 1 |